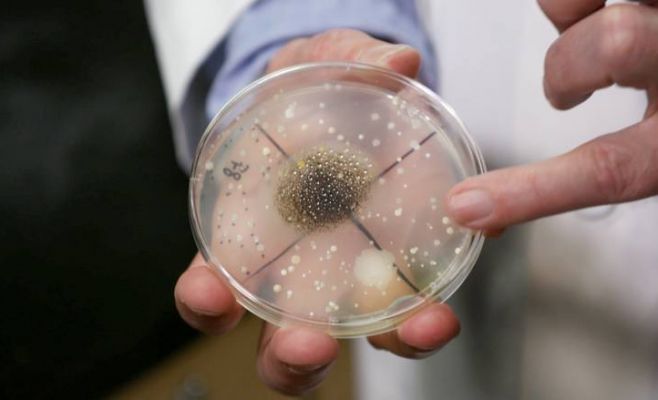

Вторая по величине экономика мира — Китай — снова сталкивается с затяжной дефляцией. В марте потребительские цены в стране снизились на 0,1% по сравнению с тем же месяцем прошлого года. Это уже второй месяц подряд, когда фиксируется дефляция: в феврале снижение составило 0,7%. И это не единичный случай — в промышленности ситуация ещё тревожнее: цены производителей упали сразу на 2,5% год к году. Такой нисходящий тренд сохраняется уже 29 месяцев подряд.
Дефляция снова в центре внимания: Китай не может выйти из порочного круга
Проблемы с дефляцией в Китае начали обостряться ещё во второй половине 2023 года. Хотя в прошлом году рост цен в стране и наблюдался, он ни разу не превысил 1% — это признак очень слабого спроса.
Некоторую надежду внушает лишь так называемая базовая инфляция — без учёта цен на продукты и топливо. В марте она выросла на 0,5% по сравнению с мартом 2024 года, тогда как в феврале было зафиксировано снижение на 0,1%. Эти данные дали повод аналитикам говорить о возможном расхождении между динамикой потребительских и производственных цен.
Эксперты: Производственные цены продолжат падение, а потребительский рынок может ожить
По словам главного экономиста Economist Intelligence Unit Тяньчэна Сюй, базовые потребительские цены демонстрируют признаки роста. Однако производственные цены, по его мнению, будут снижаться и дальше из-за торговых напряжённостей.
«Китайские экспортеры вынуждены конкурировать за сужающийся мировой рынок», — отметил Сюй, напомнив о пошлинах, введённых США. Сейчас на китайские товары действует импортная пошлина в размере 145%, что сильно бьёт по промышленному сектору страны.
Пекин делает ставку на потребление: власти готовят новые меры поддержки
На фоне падения экспорта и усиливающейся дефляции китайское правительство делает ставку на внутреннее потребление. В марте премьер Госсовета КНР Ли Цян представил доклад о работе правительства, где увеличение потребительской активности названо приоритетом №1.
Китай поставил себе амбициозную цель — рост ВВП на 5% в 2025 году. И это впервые за десятилетие, когда власти уделяют такое внимание внутреннему спросу. Как отмечает Лаура Ван из Morgan Stanley, в правительственном докладе слово «потребление» упоминалось 27 раз — это рекорд за последние десять лет.
С учётом усиливающегося давления со стороны США и их торговых барьеров, Китай планирует удвоить, а возможно, и учетверить свои усилия по стимулированию внутреннего спроса. Об этом CNBC сообщил профессор экономики университета Цинхуа и бывший советник Народного банка Китая Ли Даокуй. Он ожидает, что новые меры стимулирования будут объявлены в течение ближайших 10 дней.
Первые шаги уже сделаны: Китай удваивает потребительские субсидии
Ещё в марте власти Китая удвоили финансирование программы поддержки потребительского рынка, выделив на неё 300 миллиардов юаней (почти 927 миллиардов чешских крон). Субсидии покроют 15–20% стоимости определённых товаров — в том числе смартфонов среднего сегмента и бытовой техники.
Но хватит ли этого? Эксперты сомневаются
Тем не менее, многие аналитики не уверены, что этих шагов будет достаточно. Джулиан Эванс-Притчард из Capital Economics считает, что большая часть бюджетных средств по-прежнему уходит на развитие предложения — то есть на поддержку производства, а не спроса.
«Скорее всего, мер по стимулированию потребления окажется недостаточно, чтобы компенсировать сокращающийся экспорт. Избыточные мощности в производстве лишь усугубляют ситуацию, создавая дополнительное давление на снижение цен», — отметил он.
Дефляция: хорошая новость для кошелька, но плохая — для экономики
На первый взгляд, снижение цен — приятная новость для потребителей. Но если дефляция затягивается, она может перерасти в опасную экономическую спираль, предостерегает аналитик Citfin Томаш Вольф.
«Проблема дефляции в том, что она может быстро привести к цепной реакции. Падает цена в магазинах — компании вынуждены сокращать прибыль, затем зарплаты, производство, и, в конечном итоге, начинается волна банкротств. Всё это приводит к падению ВВП», — поясняет он.
Что дальше?
Сможет ли Китай вырваться из этого дефляционного цикла — покажет ближайшее будущее. Пока же Пекин делает ставку на оживление внутреннего спроса, надеясь, что масштабные субсидии и налоговые послабления вернут экономику на путь уверенного роста.